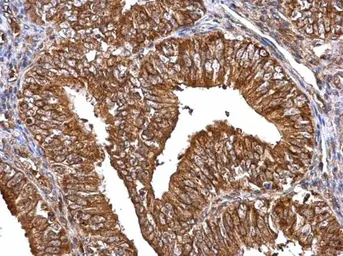

MMP2 antibody
Cat. No. GTX104577
Cat. No. GTX104577
-
HostRabbit
-
ClonalityPolyclonal
-
IsotypeIgG
-
ApplicationsWB ICC/IF IHC-P IHC-Fr IP
-
ReactivityHuman, Mouse, Rat, Pig